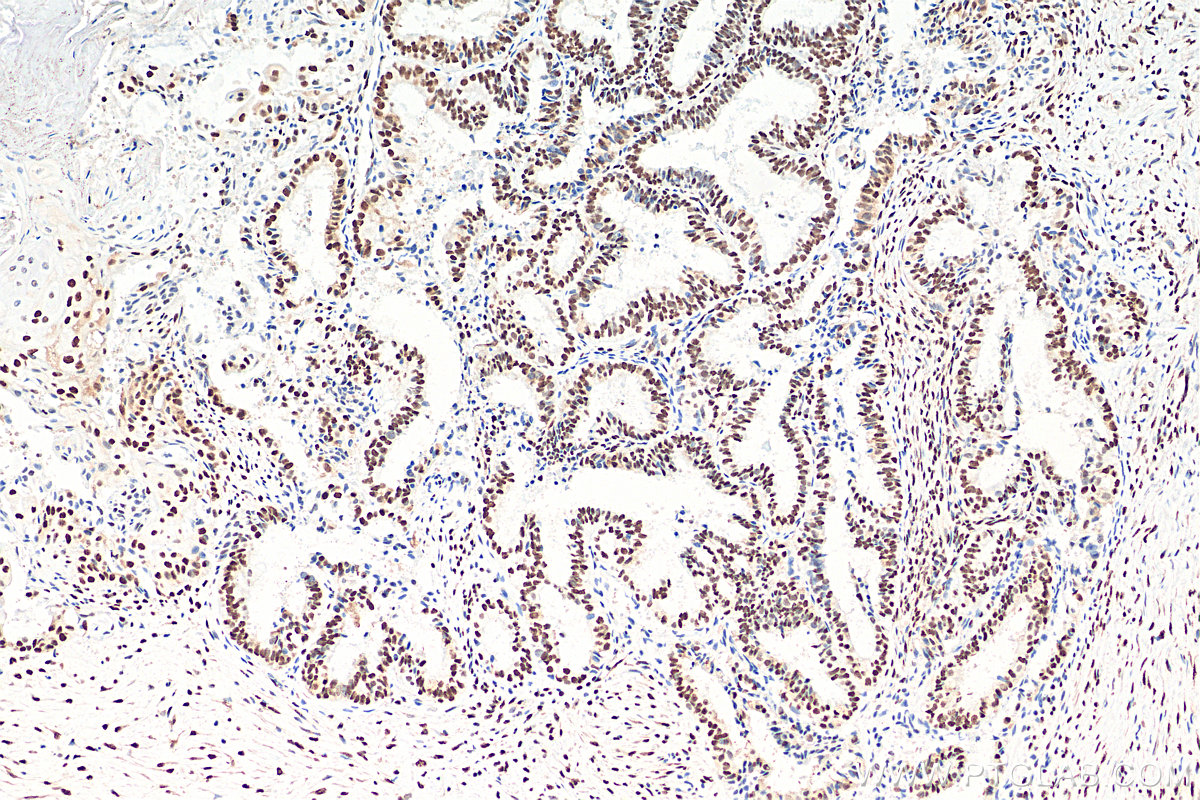

验证数据展示
经过测试的应用
| Positive WB detected in | HeLa cells, Jurkat cells, Neuro-2a cells, rat brain tissue, HepG2 cells, HEK-293 cells, mouse brain tissue |
| Positive IP detected in | K-562 cells |
| Positive IHC detected in | rat brain tissue, human ovary tumor tissue, human colon tissue, mouse brain tissue, mouse cerebellum tissue Note: suggested antigen retrieval with TE buffer pH 9.0; (*) Alternatively, antigen retrieval may be performed with citrate buffer pH 6.0 |
| Positive IF-P detected in | mouse brain tissue |
| Positive IF-Fro detected in | rat cerebellum tissue, mouse cerebellum tissue |
| Positive FC (Intra) detected in | HEK-293T cells |
推荐稀释比
| 应用 | 推荐稀释比 |
|---|---|
| Western Blot (WB) | WB : 1:5000-1:50000 |
| Immunoprecipitation (IP) | IP : 0.5-4.0 ug for 1.0-3.0 mg of total protein lysate |
| Immunohistochemistry (IHC) | IHC : 1:5000-1:20000 |
| Immunofluorescence (IF)-P | IF-P : 1:200-1:800 |
| Immunofluorescence (IF)-FRO | IF-FRO : 1:200-1:800 |
| Flow Cytometry (FC) (INTRA) | FC (INTRA) : 0.40 ug per 10^6 cells in a 100 µl suspension |
| It is recommended that this reagent should be titrated in each testing system to obtain optimal results. | |
| Sample-dependent, Check data in validation data gallery. | |
产品信息
68262-1-Ig targets FUS/TLS in WB, IHC, IF-P, IF-Fro, FC (Intra), IP, ELISA applications and shows reactivity with human, mouse, rat samples.
| 经测试应用 | WB, IHC, IF-P, IF-Fro, FC (Intra), IP, ELISA Application Description |
| 文献引用应用 | WB, IF |
| 经测试反应性 | human, mouse, rat |
| 文献引用反应性 | human, mouse, rat |
| 免疫原 |
CatNo: Ag2150 Product name: Recombinant human FUS/TLS protein Source: e coli.-derived, PGEX-4T Tag: GST Domain: 53-400 aa of BC026062 Sequence: SSYSSYGQSQNTGYGTQSTPQGYGSTGGYGSSQSSQSSYGQQSSYPGYGQQPAPSSTSGSYGSSSQSSSYGQPQSGSYSQQPSYGGQQQSYGQQQSYNPPQGYGQQNQYNSSSGGGGGGGGGGNYGQDQSSMSSGGGSGGGYGNQDQSGGGGSGGYGQQDRGGRGRGGSGGGGGGGGGGYNRSSGGYEPRGRGGGRGGRGGMGGSDRGGFNKFGGPRDQGSRHDSEQDNSDNNTIFVQGLGENVTIESVADYFKQIGIIKTNKKTGQPMINLYTDRETGKLKGEATVSFDDPPSAKAAIDWFDGKEFSGNPIKVSFATRRADFNRGGGNGRGGRGRGGPMGRGGYGGG 种属同源性预测 |
| 宿主/亚型 | Mouse / IgG1 |
| 抗体类别 | Monoclonal |
| 产品类型 | Antibody |
| 全称 | fusion (involved in t(12;16) in malignant liposarcoma) |
| 别名 | FUS, 1B4F8, 75 kDa DNA pairing protein, 75 kDa DNA-pairing protein, ALS |
| 计算分子量 | 75 kDa |
| 观测分子量 | 53 kDa, 68-75 kDa |
| GenBank蛋白编号 | BC026062 |
| 基因名称 | FUS/TLS |
| Gene ID (NCBI) | 2521 |
| RRID | AB_2935347 |
| 偶联类型 | Unconjugated |
| 形式 | Liquid |
| 纯化方式 | Protein G purification |
| UNIPROT ID | P35637 |
| 储存缓冲液 | PBS with 0.02% sodium azide and 50% glycerol, pH 7.3. |
| 储存条件 | Store at -20°C. Stable for one year after shipment. Aliquoting is unnecessary for -20oC storage. |
背景介绍
FUS (also named TLS and POMp75) belongs to the RRM TET family. FUS may play a role in the maintenance of genomic integrity; it binds both single-stranded and double-stranded DNA and promotes ATP-independent annealing of complementary single-stranded DNAs and D-loop formation in superhelical double-stranded DNA. FUS is also an RNA-binding protein, and its links to neurodegenerative disease proffer the intriguing possibility that altered RNA metabolism or RNA processing may underlie or contribute to neuron degeneration[PMID: 22640227]. FUS may be a cause of angiomatoid fibrous histiocytoma (AFH) and is implicated in certain forms of amyotrophic lateral sclerosis (ALS) and frontotemporal dementias (FTDs) such as frontotemporal lobar dementia with ubiquitin inclusions (FTLD-U)(PMID: 22640227). Multiple phosphorylation on the N terminus of FUS caused that FUS was detected 68-75 kDa (PMID:24899704).
实验方案
| Product Specific Protocols | |
|---|---|
| IF protocol for FUS/TLS antibody 68262-1-Ig | Download protocol |
| IHC protocol for FUS/TLS antibody 68262-1-Ig | Download protocol |
| IP protocol for FUS/TLS antibody 68262-1-Ig | Download protocol |
| WB protocol for FUS/TLS antibody 68262-1-Ig | Download protocol |
| Standard Protocols | |
|---|---|
| Click here to view our Standard Protocols |
发表文章
| Species | Application | Title |
|---|---|---|
Mol Cell A di-acetyl-decorated chromatin signature couples liquid condensation to suppress DNA end synapsis | ||
Mol Cell Aberrant phase separation drives membranous organelle remodeling and tumorigenesis | ||
Arterioscler Thromb Vasc Biol Exosomes From IgE-Stimulated Mast Cells Aggravate Asthma-Mediated Atherosclerosis Through circRNA CDR1as-Mediated Endothelial Cell Dysfunction in Mice | ||
Clin Exp Med FUS and METTL3 collaborate to regulate RNA maturation, preventing unfolded protein response and promoting gastric cancer progression
| ||
Nat Neurosci Mitochondrial respiratory complex IV deficiency recapitulates amyotrophic lateral sclerosis | ||
Cell Microglial-derived C1q integrates into neuronal ribonucleoprotein complexes and impacts protein homeostasis in the aging brain |